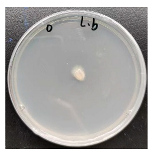
Forests 16 00413 i001
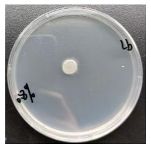
Forests 16 00413 i003
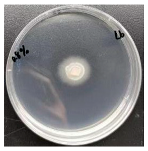
Forests 16 00413 i006
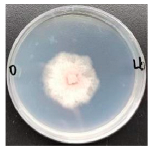
Forests 16 00413 i007
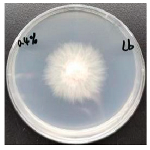
Forests 16 00413 i008
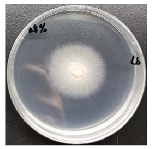
Forests 16 00413 i009
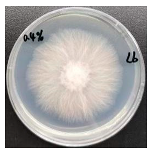
Forests 16 00413 i011

Mycorrhization of Quercus dentata Seedlings with Laccaria bicolor Enhances Salt Tolerance of Plants Only Under Relatively Moderate Soil Salinity Level
Abstract
1. Introduction
2. Materials and Methods
2.1. Seed Collection and Germination
2.2. Fungal Culture and Inoculation
2.3. NaCl Treatments
2.4. Mycorrhizal Colonization Rate Determination
2.5. Plant Measurements
2.6. Statistical Analysis
3. Results
3.1. Inoculation and Mycorrhiza Formation
3.2. Effects of L. bicolor Inoculation on Growth Indicators Under Salt Stress
3.3. Effects of L. bicolor on Physiological Indicators Under Salt Stress
4. Discussion
4.1. Response of Q. dentata Seedlings to NaCl Treatment
4.2. Positive Effects of L. bicolor on Q. dentata Seedlings Under Moderate Salinity
4.3. Negative Effects of L. bicolor on Q. dentata Seedlings Under High Salinity
4.4. Implications for Afforestation Activities in Saline Areas
5. Conclusions
Author Contributions
Funding
Data Availability Statement
Acknowledgments
Conflicts of Interest
Abbreviations
| EMF | Ectomycorrhizal fungi |
| SLA | Specific leaf area |
| RMR | Root mass ratio |
| SMR | Stem mass ratio |
| LMR | Leaf mass ratio |
Appendix A
Appendix A.1
| Plant Traits | F Value and Its Significance | ||
|---|---|---|---|
| Fungus Inoculation | Soil Salinity | Interaction Effects | |
| Height (cm) | 0.094 | 1.798 | 0.161 |
| Basal diameter (mm) | 0.661 | 17.46 *** | 2.733 |
| Leaf water content (%) | 5.547 * | 485.198 *** | 3.277 |
| SLA (cm2 g−1) | 16.562 *** | 6.131 ** | 0.652 |
| Total biomass (g) | 8.486 *** | 115.954 *** | 6.165 *** |
| Root biomass (g) | 31.085 *** | 251.122 *** | 14.307 *** |
| Stem biomass (g) | 1.096 | 38.333 *** | 1.185 |
| Leaf biomass (g) | 0.952 | 29.783 *** | 1.934 |
| RMR | 4.305 * | 17.907 *** | 0.070 |
| SMR | 0.663 | 0.163 | 0.194 |
| LMR | 4.096 | 30.781 *** | 0.173 |
| R/S | 5.920 *** | 24.919 *** | 0.383 |
| Net photosynthetic rate (μmol m−2 s−1) | 0.568 | 40.001 *** | 1.506 |
| Transpiration rate (mmol m−2 s−1) | 0.375 | 40.475 *** | 0.573 |
| Instantaneous water use efficiency (mmol mol−1) | 0.381 | 3.000 | 1.003 |
| Stomatal conductance (mol m−2 s−1) | 1.668 | 54.428 *** | 1.571 |
| Chlorophyll a (mg g−1) | 3.391 * | 31.083 *** | 2.083 |
| Chlorophyll b (mg g−1) | 4.534 * | 3.657 * | 0.501 |
| Total chlorophyll (mg g−1) | 4.428 * | 17.895 *** | 1.508 |
| Chlorophyll a/b | 0.486 | 34.169 *** | 0.419 |
| Maximum quantum yield of photosystem II | 1.353 | 11.559 *** | 1.705 |
| Photochemical quenching | 12.054 ** | 140.885 *** | 15.256 *** |
| Relative electron transport rate of photosystem I (µmol m−2 s−1) | 1.259 | 51.444 ** | 2.002 |
| Actual quantum yield of photosystem I | 1.292 | 51.809 *** | 1.995 |
| Relative electron transport rate of photosystem II (µmol m−2 s−1) | 0.441 | 42.891 *** | 0.093 |
| Actual quantum yield of photosystem II | 0.447 | 42.682 *** | 0.093 |
| Root Na+ content | 0.393 | 23.507 *** | 0.197 |
| Stem Na+ content | 2.779 | 93.984 *** | 0.198 |
| Leaf Na+ content | 19.099 ** | 219.260 *** | 5.476 * |
| Root K+ content | 2.749 | 2.621 | 0.539 |
| Stem K+ content | 1.616 | 4.605 * | 3.282 |
| Leaf K+ content | 3.831 | 3.138 | 2.795 |
| Root Ca2+ content | 0.453 | 2.890 | 2.382 |
| Stem Ca2+ content | 2.239 | 6.655 * | 1.624 |
| Leaf Ca2+ content | 0.338 | 2.890 | 1.367 |
| Root Mg2+ content | 0.031 | 0.819 | 0.043 |
| Stem Mg2+ content | 2.165 | 1.771 | 0.277 |
| Leaf Mg2+ content | 0.748 | 1.560 | 0.374 |
| Sodium–potassium ratio | 0.061 | 43.960 *** | 1.858 |
| Root nitrogen content | 1.130 | 4.922 * | 4.541 * |
| Root phosphorus content | 2.221 | 6.621 ** | 0.025 |
| Stem nitrogen content | 0.140 | 4.511 * | 2.253 |
| Stem phosphorus content | 0.004 | 3.489 | 0.040 |
| Leaf nitrogen content | 0.571 | 2.949 | 1.756 |
| Leaf phosphorus content | 0.569 | 0.237 | 2.136 |
Appendix A.2
| Growth Time | NaCl Content in the Culture Medium | ||
|---|---|---|---|
| 0 | 0.4% | 0.8% | |
| One day | ![]() | ![]() | ![]() |
| Three days | ![]() | ![]() | ![]() |
| Five days | ![]() | ![]() | ![]() |
| Seven days | ![]() | ![]() | ![]() |
References
- Kopittke, P.M.; Menzies, N.W.; Wang, P.; McKenna, B.A.; Lombi, E. Soil and the intensification of agriculture for global food security. Environ. Int. 2019, 132, 105078. [Google Scholar] [CrossRef] [PubMed]
- Singh, A. Soil salinization management for sustainable development: A review. J. Environ. Manag. 2021, 277, 111383. [Google Scholar] [CrossRef] [PubMed]
- Negacz, K.; Malek, Z.; de Vos, A.; Vellinga, P. Saline soils worldwide: Identifying the most promising areas for saline agriculture. J. Arid Environ. 2022, 203, e104775. [Google Scholar] [CrossRef]
- Ullah, S.; Dahlawi, S.; Naeem, A.; Rengel, Z.; Naidu, R. Biochar application for the remediation of salt-affected soils: Challenges and opportunities. Sci. Total. Environ. 2017, 625, 320–335. [Google Scholar]
- Mukhopadhyay, R.; Sarkar, B.; Jat, H.S.; Sharma, P.C.; Bolan, N.S. Soil salinity under climate change: Challenges for sustainable agriculture and food security. J. Environ. Manag. 2021, 280, 111736. [Google Scholar] [CrossRef]
- Crooks, S.; Sutton-Grier, A.E.; Troxler, T.G.; Herold, N.; Bernal, B.; Schile-Beers, L.; Wirth, T. Coastal wetland management as a contribution to the US National Greenhouse Gas Inventory. Nat. Clim. Change 2018, 8, 1109–1112. [Google Scholar] [CrossRef]
- Litalien, A.; Zeeb, B. Curing the earth: A review of anthropogenic soil salinization and plant-based strategies for sustainable mitigation. Sci. Total Environ. 2020, 698, 134235. [Google Scholar] [CrossRef]
- Van Zelm, E.V.; Zhang, Y.X.; Testerink, C. Salt tolerance mechanisms of plants. Annu. Rev. Plant Biol. 2020, 71, 403–433. [Google Scholar] [CrossRef]
- Hao, S.H.; Wang, Y.R.; Yan, Y.X.; Liu, Y.H.; Wang, J.Y.; Chen, S. A review on plant responses to salt stress and their mechanisms of salt resistance. Horticulturae 2021, 7, 132. [Google Scholar] [CrossRef]
- Ruan, C.J.; de Silva, J.A.T.; Mopper, S.; Qin, P.; Lutt, S. Halophyte improvement for a salinized world. Crit. Rev. Plant Sci. 2010, 29, 329–359. [Google Scholar] [CrossRef]
- Manousaki, E.; Kalogerakis, N. Halophytes—An emerging trend in phytoremediation. Int. J. Phytoremediat 2011, 13, 959–969. [Google Scholar] [CrossRef] [PubMed]
- Stavi, I.; Thevs, N.; Priori, S. Soil salinity and sodicity in drylands: A review of causes, effects, monitoring, and restoration measures. Front. Environ. Sci. 2021, 9, 712831. [Google Scholar] [CrossRef]
- Manousaki, E.; Kalogerakis, N. Halophytes present new opportunities in phytoremediation of heavy metals and saline soils. Ind. Eng. Chem. Res. 2011, 50, 656–660. [Google Scholar] [CrossRef]
- Liang, L.C.; Liu, W.T.; Sun, Y.B.; Huo, X.H.; Li, S.; Zhou, Q.X. Phytoremediation of heavy metal contaminated saline soils using halophytes: Current progress and future perspectives. Environ. Rev. 2017, 25, 269–281. [Google Scholar] [CrossRef]
- Kremer, A.; Hipp, A.L. Oaks: An evolutionary success story. New Phytol. 2019, 226, 987–1011. [Google Scholar] [CrossRef]
- Sork, V.L.; Cokus, S.J.; Fitz-Gibbon, S.T.; Zimin, A.V.; Puiu, D.; Garcia, J.A.; Gugger, P.F.; Henriquez, C.L.; Zhen, Y.; Lohmueller, K.E.; et al. High-quality genome and methylomes illustrate features underlying evolutionary success of oaks. Nat. Commun. 2022, 13, 2047. [Google Scholar] [CrossRef]
- Alaoui-Sossé, B.; Sehmer, L.; Barnola, P.; Dizengremel, P. Effect of NaCl salinity on growth and mineral partitioning in Quercus robur L. a rhythmically growing species. Trees 1998, 12, 424–430. [Google Scholar] [CrossRef]
- Wang, S.F.; Hu, Y.X.; Sun, H.J.; Shi, X.; Pan, H.W.; Chen, Y.T. Effects of salt stress on growth and root development of two oak seedlings. Acta. Ecol. Sin. 2014, 34, 1021–1029. [Google Scholar]
- Gugliuzza, G.; Gentile, C.; Scuderi, D.; Palazzolo, E.; Farina, V. Effects of salt stress on growth of Quercus ilex L. seedlings. Open Agric. 2023, 8, 20220211. [Google Scholar] [CrossRef]
- Jesus, J.M.; Danko, A.S.; Fiúza, A.; Borges, M.T. Phytoremediation of salt-affected soils: A review of processes, applicability, and the impact of climate change. Environ. Sci. Pollut. R. 2015, 22, 6511–6525. [Google Scholar] [CrossRef]
- Muhsin, T.M.; Zwiazek, J.J. Colonization with Hebeloma crustuliniforme increases water conductance and limits shoot sodium uptake in white spruce (Picea glauca) seedlings. Plant Soil 2002, 238, 217–225. [Google Scholar] [CrossRef]
- Begum, N.; Qin, C.; Ahanger, M.A.; Raza, S.; Khan, M.I.; Ashraf, M.; Ahmed, N.; Zhang, L.X. Role of Arbuscular Mycorrhizal Fungi in Plant Growth Regulation: Implications in Abiotic Stress Tolerance. Front. Plant Sci. 2019, 10, 1068. [Google Scholar] [CrossRef] [PubMed]
- Klinsukon, C.; Lumyong, S.; Kuyper, T.W.; Boonlue, S. Colonization by arbuscular mycorrhizal fungi improves salinity tolerance of eucalyptus (Eucalyptus camaldulensis) seedlings. Sci. Rep. 2021, 11, 4362. [Google Scholar] [CrossRef] [PubMed]
- Peng, Z.C.; Zulfiqar, T.; Yang, H.C.; Wang, M.; Zhang, F.H. Effect of Arbuscular Mycorrhizal Fungi (AMF) on photosynthetic characteristics of cotton seedlings under saline-alkali stress. Sci. Rep. 2024, 14, 8633. [Google Scholar] [CrossRef]
- Arai, H.; Tamai, Y.; Yajima, T.; Obase, K.; Miyamato, T. Ectomycorrhizal fungal communities associated with Quercus dentata in a coastal broadleaf forest. Mycosphere 2017, 8, 561–567. [Google Scholar] [CrossRef]
- Guerrero-Galán, C.; Calvo-Polanco, M.; Zimmermann, S.D. Ectomycorrhizal symbiosis helps plants to challenge salt stress conditions. Mycorrhiza 2019, 29, 291–301. [Google Scholar] [CrossRef]
- Guo, W.; Hao, H.; Zhang, W.H.; Hu, Z.H.; Leng, P.S. Ectomycorrhizal fungi enhance salt tolerance of Quercus mongolica by regulating ion balance. Chin. J. Appl. Ecol. 2022, 33, 3303–3311. [Google Scholar]
- Bai, X.N.; Hao, H.; Hu, Z.H.; Leng, P.S. Ectomycorrhizal inoculation enhances the salt tolerance of Quercus mongolica seedlings. Plants 2021, 10, 1790. [Google Scholar] [CrossRef]
- Bois, G.; Bigras, F.J.; Bertrand, A.; Piché, Y.; Fung, M.Y.P.; Khasa, D.P. Ectomycorrhizal fungi affect the physiological responses of Picea glauca and Pinus banksiana seedlings exposed to an NaCl gradient. Tree Physiol. 2006, 26, 1185–1196. [Google Scholar] [CrossRef]
- Tang, M.; Sheng, M.; Chen, H.; Zhang, F.F. In vitro salinity resistance of three ectomycorrhizal fungi. Soil Biol. Biochem. 2009, 41, 948–953. [Google Scholar] [CrossRef]
- Zhou, B.F.; Shi, Y.; Chen, X.Y.; Yuan, S.; Liang, Y.Y.; Wang, B.S. Linked selection, ancient polymorphism, and ecological adaptation shape the genomic landscape of divergence in Quercus dentata. J. Syst. Evol. 2022, 60, 1344–1357. [Google Scholar] [CrossRef]
- Hao, H.; Cao, L.; Chen, W.N.; Hu, Z.H.; Leng, P.S. Effects of salt stress on the ion balance and physiological-biochemical characteristics of Quercus dentata seedlings. Acta. Ecol. Sin. 2020, 40, 6897–6904. [Google Scholar]
- Qiu, Z.L.; Zhang, M.; Wang, K.F.; Shi, F.C. Vegetation community dynamics during naturalized developmental restoration of Pinus tabulaeformis plantation in North warm temperate zone. J. Plant Ecol. 2023, 16, rtac102. [Google Scholar] [CrossRef]
- Martin, F.; Aerts, A.; Ahrén, D.; Brun, A.; Danchin, E.G.J.; Duchaussoy, F.; Gibon, J.; Kohler, A.; Lindquist, E.; Pereda, V.; et al. The genome of Laccaria bicolor provides insights into mycorrhizal symbiosis. Nature 2008, 452, 88–92. [Google Scholar] [CrossRef] [PubMed]
- Polanco, M.C.; Zwiazek, J.J.; Voicu, M.C. Responses of ectomycorrhizal American elm (Ulmus americana) seedlings to salinity and soil compaction. Plant Soil 2008, 308, 189–200. [Google Scholar] [CrossRef]
- Xu, H.; Kemppainen, M.; El Kayal, W.; Lee, S.H.; Pardo, A.G.; Cooke, J.E.K.; Zwiazek, J.J. Overexpression of Laccaria bicolor aquaporin JQ585595 alters root water transport properties in ectomycorrhizal white spruce (Picea glauca) seedlings. New Phytol. 2015, 205, 757–770. [Google Scholar] [CrossRef]
- Plett, J.M.; Kemppainen, M.; Kale, S.D.; Kohler, A.; Legué, V.; Brun, A.; Tyler, B.M.; Pardo, A.G.; Martin, F. A secreted effector protein of Laccaria bicolor is required for symbiosis development. Curr. Biol. 2011, 21, 1197–1203. [Google Scholar] [CrossRef]
- Shi, N.N.; Guo, C.; Zheng, Y.; Guo, L.D. Effects of ectomycorrhizal fungal identity and diversity on subtropical tree competition. J. Plant Ecol. 2017, 10, 47–55. [Google Scholar] [CrossRef]
- Wang, Z.Q. Saline Soils in China, 1st ed.; Science Press: Beijing, China, 1993; pp. 133–139. [Google Scholar]
- Phillips, J.M.; Hayman, D.S. Improved procedures for clearing roots and staining parasitic and vesicular-arbuscular mycorrhizal fungi for rapid assessment of infection. Trans. Br. Mycol. Soc. 1970, 55, 158–160. [Google Scholar] [CrossRef]
- Lu, C.M.; Zhang, J.H. Effects of water stress on photosystem II photochemistry and its thermostability in wheat plants. J. Exp. Bot. 1999, 50, 1199–1206. [Google Scholar] [CrossRef]
- Maxwell, K.; Johnson, G.N. Chlorophyll fluorescence—A practical guide. J. Exp. Bot. 2000, 51, 659–668. [Google Scholar] [CrossRef] [PubMed]
- Lichtenthaler, H.K.; Wellburn, A.R. Determinations of total carotenoids and chlorophylls a and b of leaf extracts in different solvents. Biochem. Soc. T. 1983, 11, 591–592. [Google Scholar] [CrossRef]
- Mao, P.L.; Zhang, Y.J.; Cao, B.H.; Guo, L.M.; Shao, H.B.; Cao, Z.Y.; Jiang, Q.K.; Wang, X. Effects of salt stress on eco-physiological characteristics in Robinia pseudoacacia based on salt-soil rhizosphere. Sci. Total Environ. 2016, 568, 118–123. [Google Scholar] [CrossRef] [PubMed]
- Patel, N.T.; Gupta, A.; Pandey, A.N. Strong positive growth responses to salinity by Ceriops tagal, a commonly occurring mangrove of the Gujarat coast of India. AoB. Plants 2010, 2010, pjq011. [Google Scholar] [CrossRef]
- Horie, T.; Hauser, F.; Schroeder, J.I. HKT transporter-mediated salinity resistance mechanisms in Arabidopsis and monocotcrop plants. Trends Plant Sci. 2009, 14, 660–668. [Google Scholar] [CrossRef]
- Hammer, E.C.; Nasr, H.; Pallon, J.; Olsson, P.A.; Wallander, H. Elemental composition of arbuscular mycorrhizal fungi at high salinity. Mycorrhiza 2011, 21, 117–129. [Google Scholar] [CrossRef]
- Heng, T.; He, X.L.; Yang, G.; Tian, L.J.; Li, F.D.; Yang, L.L.; Zhao, L.; Feng, Y.; Xu, X. Growth and nitrogen status of cotton (Gossypium hirsutum L.) under salt stress revealed using 15N-labeled fertilizer. J. Plant Ecol. 2022, 15, 1213–1226. [Google Scholar] [CrossRef]
- Pardo, J.M. Biotechnology of water and salinity stress tolerance. Curr. Opin. Biotech. 2010, 21, 185–196. [Google Scholar] [CrossRef]
- Li, J.M.; Hu, L.P.; Zhang, L.; Pan, X.B.; Hu, X.H. Exogenous spermidine is enhancing tomato tolerance to salinity–alkalinity stress by regulating chloroplast antioxidant system and chlorophyll metabolism. BMC Plant Biol. 2015, 15, 303. [Google Scholar] [CrossRef]
- Akram, M. Effects of nitrogen application on chlorophyll content, water relations, and yield of maize hybrids under saline conditions. Commun. Soil Sci. Plan. 2014, 45, 1336–1356. [Google Scholar] [CrossRef]
- Sudhir, P.; Murthy, S.D.S. Effects of salt stress on basic processes of photosynthesis. Photosynthetica 2004, 42, 481–486. [Google Scholar] [CrossRef]
- Bose, J.; Munns, R.; Shabala, S.; Gilliham, M.; Pogson, B.; Tyerman, S. Chloroplast function and ion regulation in plants growing on saline soils: Lessons from halophytes. J. Exp. Bot. 2017, 68, 3129–3143. [Google Scholar] [CrossRef]
- Tombesi, S.; Nardini, A.; Frioni, T.; Soccolini, M.; Zadra, C.; Farinelli, D.; Poni, S.; Palliotti, A. Stomatal closure is induced by hydraulic signals and maintained by ABA in drought-stressed grapevine. Sci. Rep. 2015, 5, 12449. [Google Scholar] [CrossRef] [PubMed]
- Zahra, N.; Al Hinai, M.S.; Hafeez, M.B.; Rehman, A.; Wahid, A.; Siddique, K.H.M.; Farooq, M. Regulation of photosynthesis under salt stress and associated tolerance mechanisms. Plant Physiol. Bioch. 2022, 178, 55–69. [Google Scholar] [CrossRef] [PubMed]
- Gururani, M.A.; Venkatesh, J.; Tran, L.P. Regulation of photosynthesis during abiotic stress-induced photoinhibition. Mol. Plant 2015, 8, 1304–1320. [Google Scholar] [CrossRef] [PubMed]
- Humeed, A.; Ahmed, M.Z.; Hussain, T.; Aziz, I.; Ahmad, N.; Gul, B.; Nielsen, B.L. Effects of salinity stress on chloroplast structure and function. Cells 2021, 10, 2023. [Google Scholar] [CrossRef]
- Genre, A.; Lanfranco, L.; Perotto, S.; Bonfante, P. Unique and common traits in mycorrhizal symbioses. Nat. Rev. Microbiol. 2020, 18, 649–660. [Google Scholar] [CrossRef]
- Bahadur, A.; Batool, A.; Nasir, F.; Jiang, S.J.; Qin, M.S.; Zhang, Q.; Pan, J.B.; Liu, Y.J.; Feng, H.Y. Mechanistic insights into arbuscular mycorrhizal fungi-mediated drought stress tolerance in plants. Int. J. Mol. Sci. 2019, 20, 4199. [Google Scholar] [CrossRef]
- Wang, R.Z.; Chen, L.; Bai, Y.G.; Xiao, C.W. Seasonal dynamics in resource partitioning to growth and storage in response to drought in a perennial rhizomatous grass, Leymus chinensis. J. Plant Growth Regul. 2008, 27, 39–48. [Google Scholar] [CrossRef]
- Al-Khaliel, A.S. Effect of salinity stress on mycorrhizal association and growth response of peanut infected by Glomus mosseae. Plant Soil Environ. 2010, 56, 318–324. [Google Scholar] [CrossRef]
- Tilak, K.V.B.R.; Ranganayaki, N.; Manoharachari, C. Synergistic effects of plant-growth promoting rhizobacteria and Rhizobium on nodulation and nitrogen fixation by pigeonpea (Cajanus cajan). Eur. J. Soil Sci. 2006, 57, 67–71. [Google Scholar] [CrossRef]
- Douglas, A.E. Conflict, cheats and the persistence of symbioses. New Phytol. 2008, 177, 849–858. [Google Scholar] [CrossRef] [PubMed]
- Bonfante, P.; Genre, A. Mechanisms underlying beneficial plant–fungus interactions in mycorrhizal symbiosis. Nat. Commun. 2010, 1, 48. [Google Scholar] [CrossRef] [PubMed]
- Kiers, E.T.; Duhamel, M.; Beesetty, Y.; Mensah, J.A.; Franken, O.; Verbruggen, E.; Fellbaum, C.R.; Kowalchuk, G.A.; Hart, M.M.; Bago, A. Reciprocal rewards stabilize cooperation in the mycorrhizal symbiosis. Science 2011, 333, 880–882. [Google Scholar] [CrossRef] [PubMed]
- Johnson, N.C.; Graham, J.H.; Smith, F.A. Functioning of mycorrhizal associations along the mutualism-parasitism continuum. New Phytol. 1997, 135, 575–585. [Google Scholar] [CrossRef]
- Kaldorf, M.; Koch, B.; Rexer, K.H.; Kost, G.; Varma, A. Patterns of interaction between Populus Esch5 and Piriformospora indica: A transition from mutualism to antagonism. Plant Biol. 2005, 7, 210–218. [Google Scholar] [CrossRef]
- Bois, G.; Bertrand, A.; Piche, Y.; Fung, M.; Khasa, D.P. Growth, compatible solute and salt accumulation of five mycorrhizal fungal species grown over a range of NaCl concentrations. Mycorrhiza 2006, 16, 99–109. [Google Scholar] [CrossRef]
- Flowers, T.J.; Munns, R.; Colmer, T.D. Sodium chloride toxicity and the cellular basis of salt tolerance in halophytes. Ann. Bot. 2015, 115, 419–431. [Google Scholar] [CrossRef]
- Li, Z.P.; Zhang, W.H.; Cui, Y.C. Effects of NaCl and Na2CO3 stresses on seed germination and seedling growth of Quercus variabilis. Acta. Ecol. Sin. 2015, 35, 742–751. [Google Scholar]
- Zhang, Z.; Wang, M.J.; Zhang, X.J.; Wang, W.B.; He, X.F.; Wang, R.; Wang, C.; Leng, P.S.; Mladenov, P.; Wang, W.H.; et al. Genome-wide identification and expression analysis of the ZIP gene family in Quercus dentata. Curr. Plant Biol. 2023, 35–36, 100291. [Google Scholar] [CrossRef]
- Zhao, Z.P.; Xie, B.; Wang, X.N.; Wang, Q.; Guo, C.; Zhang, F.; Wang, H.R.; Zhang, R.J.; Zhang, C. Adaptive growth strategies of Quercus dentata to drought and nitrogen enrichment: A physiological and biochemical perspective. Front. Plant Sci. 2024, 15, 1479563. [Google Scholar] [CrossRef] [PubMed]
- Liese, R.; Lübbe, T.; Albers, N.W.; Meier, I.C. The mycorrhizal type governs root exudation and nitrogen uptake of temperate tree species. Tree Physiol. 2018, 38, 83–95. [Google Scholar] [CrossRef] [PubMed]
- Hong, S.B.; Piao, S.L.; Chen, A.P.; Liu, Y.W.; Liu, L.L.; Peng, S.S.; Sardans, J.; Sun, Y.; Peñuelas, J.; Zeng, H. Afforestation neutralizes soil pH. Nat. Commun. 2018, 9, 520. [Google Scholar] [CrossRef] [PubMed]
- Yuan, C.X.; Wu, F.Z.; Peng, Y.; Wu, Q.Q.; Zhu, G.Q.; Zhao, Z.M.; Wang, Y.Q.; An, N.N.; Ni, X.Y.; Yue, K. Pain or gain: The dual role of afforestation effects on soil pH at the global scale. Plant Soil 2023, 493, 617–628. [Google Scholar] [CrossRef]
- Huang, Y.; Mónica, C.P.; Michael, D.M.; Janusz, J.Z. Responses of ectomycorrhizal Populus tremuloides and Betula papyrifera seedlings to salinity. Environ. Exp. Bot. 2008, 62, 357–363. [Google Scholar]
- Qin, Y.; Pan, X.Y.; Kubicek, C.; Druzhinina, I.; Chenthamara, K.; Labbé, J.; Yuan, Z.L. Diverse plant-associated pleosporalean fungi from saline areas: Ecological tolerance and nitrogen-status dependent effects on plant growth. Front. Microbiol. 2017, 8, 158. [Google Scholar] [CrossRef]
- Kernaghan, G.; Hambling, B.; Fung, M.; Khasa, D.J.R.E. In vitro selection of boreal ectomycorrhizal fungi for use in reclamation of saline-alkaline habitats. Restor. Ecol. 2002, 10, 43–51. [Google Scholar] [CrossRef]









| Treatment | Soil Salinity | Root Colonization Rate (%) |
|---|---|---|
| CK | 0 | 0 |
| 0.4% NaCl | 0 | |
| 0.8% NaCl | 0 | |
| L.b | 0 | 48 ± 8 a |
| 0.4% NaCl | 50 ± 5 a | |
| 0.8% NaCl | 22 ± 3 b |
Disclaimer/Publisher’s Note: The statements, opinions and data contained in all publications are solely those of the individual author(s) and contributor(s) and not of MDPI and/or the editor(s). MDPI and/or the editor(s) disclaim responsibility for any injury to people or property resulting from any ideas, methods, instructions or products referred to in the content. |
© 2025 by the authors. Licensee MDPI, Basel, Switzerland. This article is an open access article distributed under the terms and conditions of the Creative Commons Attribution (CC BY) license (https://creativecommons.org/licenses/by/4.0/).
Share and Cite
Sun, W.; Qi, L.; Chen, H.; Song, Y.; Jiang, J.; Zhang, P.; Wang, B.; Wang, Q.; Meng, G.; Ji, T.; et al. Mycorrhization of Quercus dentata Seedlings with Laccaria bicolor Enhances Salt Tolerance of Plants Only Under Relatively Moderate Soil Salinity Level. Forests 2025, 16, 413. https://doi.org/10.3390/f16030413
Sun W, Qi L, Chen H, Song Y, Jiang J, Zhang P, Wang B, Wang Q, Meng G, Ji T, et al. Mycorrhization of Quercus dentata Seedlings with Laccaria bicolor Enhances Salt Tolerance of Plants Only Under Relatively Moderate Soil Salinity Level. Forests. 2025; 16(3):413. https://doi.org/10.3390/f16030413
Chicago/Turabian StyleSun, Wenlong, Luyu Qi, Haonan Chen, Yixin Song, Jiaqi Jiang, Puyi Zhang, Bojian Wang, Qiang Wang, Gaode Meng, Tianyu Ji, and et al. 2025. "Mycorrhization of Quercus dentata Seedlings with Laccaria bicolor Enhances Salt Tolerance of Plants Only Under Relatively Moderate Soil Salinity Level" Forests 16, no. 3: 413. https://doi.org/10.3390/f16030413
APA StyleSun, W., Qi, L., Chen, H., Song, Y., Jiang, J., Zhang, P., Wang, B., Wang, Q., Meng, G., Ji, T., Sun, X., Guo, W., Du, N., & Zwiazek, J. J. (2025). Mycorrhization of Quercus dentata Seedlings with Laccaria bicolor Enhances Salt Tolerance of Plants Only Under Relatively Moderate Soil Salinity Level. Forests, 16(3), 413. https://doi.org/10.3390/f16030413